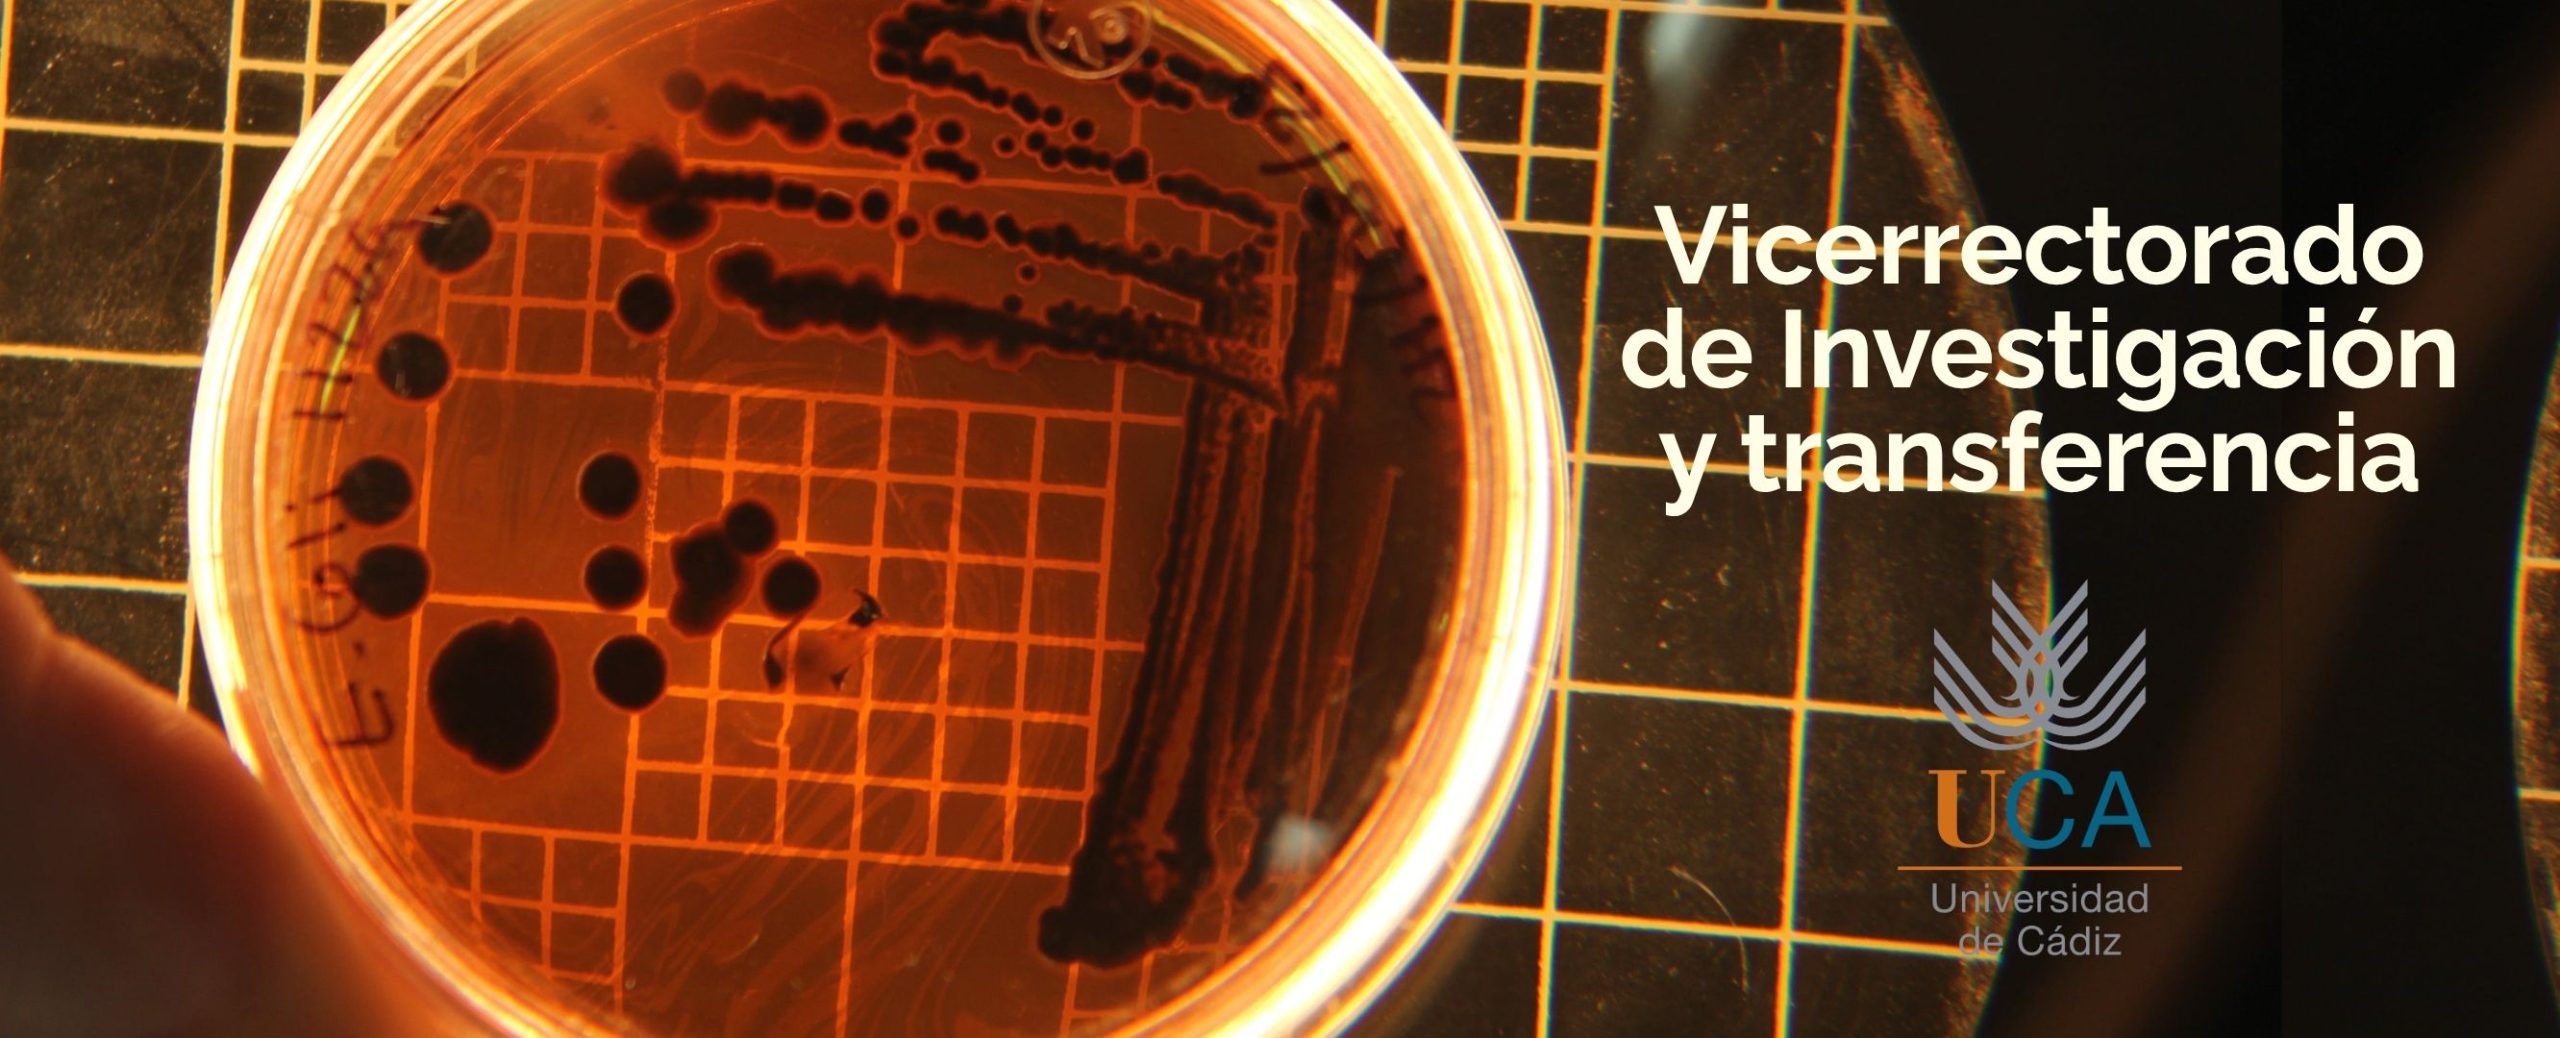

Investigación

El dolor y las enfermedades del hombre nos han acompañado en el pasado y nos seguirán acompañando en el futuro. La Medicina intenta encender luces para aliviar con su arte y su ciencia los males que aquejan la salud de la humanidad. La Ciencia robustece con su calidad y rigurosidad la respuesta a esos interrogantes. Quienes formamos parte de la población de investigadores de la Medicina recorremos un difícil camino de oscuridades y dudas. Nuestros escudos son el cultivo de actitudes, aptitudes y destrezas para saber preguntarnos sobre los fenómenos de la naturaleza humana y encontrar respuestas acertadas. Sabemos que estas respuestas necesitan el permanente contraste con la realidad. Sabemos también que el resultado de nuestro esfuerzo investigativo no nos pertenece, sino que forma parte del conocimiento universal. Recordemos que las múltiples tecnologías utilizadas en el descubrimiento de los fenómenos biomédicos tienen un faro, un único destino final: la persona humana.